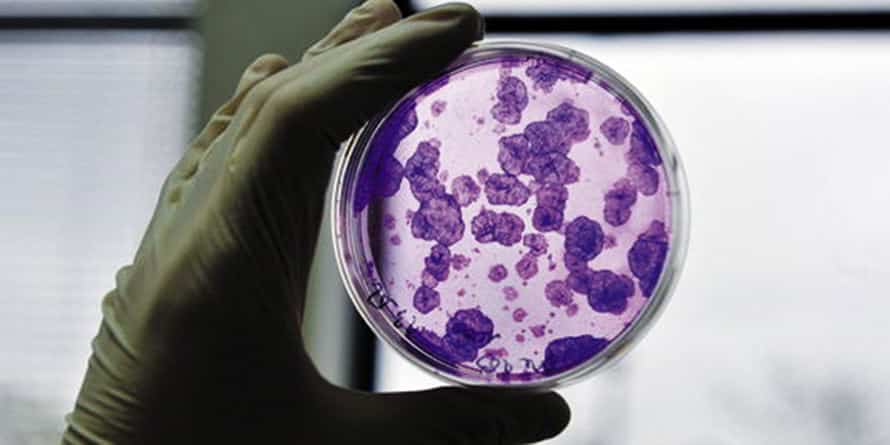
conference cellules souches

Conférence «Les cellules souches»
Mercredi 22 avril, Vendôme, 14h30, au Minotaure
Les cellules souches par le Docteur Christel Monville, Professeur à l’université d’Evry Val d’Essonne et chercheuse à l’ISTEM*, à l’appui d’un film d’une vingtaine de minutes.
« Les cellules souches font régulièrement la une des journaux tant leur utilisation en médecine semble prometteuse.
Partout dans le monde des recherches ont lieu en ce sens et des premiers résultats positifs ont déjà été obtenus.
Ainsi, l’année dernière pour la première fois, deux patientes atteintes de la maladie de la rétine ont reçu une greffe de cellules.
Mais c’est quoi une cellule souche ?
Une cellule souche est une cellule capable de s’auto renouveler et de donner naissance à plusieurs types cellulaires. »
* Institut des cellules Souches pour le Traitement et l’Étude des maladies Monogéniques.




